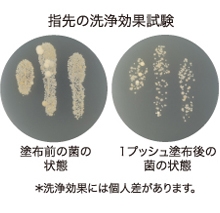

防災の日から5日間限定でグッズを見直すキャンペーンを実施 「水のいらないボディ&ヘアウォッシュ」をプレゼント!
天然原料を使った化粧品の製造・販売を手がける株式会社ルバンシュ(本社:石川県能美市/代表取締役:千田 和弘)は、9月1日(金)の「防災の日」から5日間限定で実施する、「防災グッズを見直そう!」キャンペーンにおいて、防災グッズとしても活躍する、水を使わない全身洗浄料「水のいらないボディ&ヘアウォッシュ」を、ルバンシュ通販サイトをご利用のお客様にもれなくプレゼントいたします。

キャンペーン概要
実施期間 :2017年9月1日(金)13時~2017年9月5日(火)13時
条件 :ルバンシュ通販( http://www.revanche.jp/ )で
期間中1,000円(税抜価格)以上をご購入のお客様
賞品 :水のいらないボディ&ヘアウォッシュ(現品) 1本
「防災グッズを見直そう!」キャンペーン
「水のいらないボディ&ヘアウォッシュ」は、2011年の東日本大震災をきっかけに開発された商品です。震災直後、各メーカーが販売する「ドライシャンプー」の品薄状態が続く事態を解消すべく、前身商品の全身洗浄料「水のいらないシャンプー」を緊急開発して、被災地支援の一環として同年5月から被災地などに無償提供を行いました。そのような開発経緯から、同商品をもっと防災グッズとして役立てていただきたいという願いからキャンペーンを実施いたします。
防災グッズとしてはもちろん、日常の様々なシーンで幅広く使える
水を使わない全身洗浄料として、災害時はもちろん、日常の幅広い用途とシーンで使えます。「怪我で入浴できないとき」や「外回りの営業で汗をかいたとき」、「散歩帰りの犬や猫のペットに」、「キャンプ」、「介護」、など。髪や頭皮の洗浄はもちろん、ボディの洗浄、手の洗浄などに使えます。ムース状の泡を洗浄したい部分につけて、タオルで拭き取るだけで嫌な汚れもスッキリ清潔に。グレープフルーツの爽やかな香りで、心身ともにリフレッシュさせてくれます。
また、日頃から使い慣れたグッズを防災グッズとして備えておくことで、災害時に「使い方が分からない」や「上手く使えない」といった事態を防ぐことができます。
口に入っても大丈夫な食用成分100%
口に入っても大丈夫な食用成分かつ、天然由来の成分のみを使用しています。例えば、消臭成分には緑茶成分、抗菌・洗浄成分にはサトウキビやヤシ由来の成分を使用しています。口に入っても大丈夫な成分なので、毛づくろいで身体を舐める犬や猫のペット用のドライシャンプーとしても安心して使えます。
使用方法
頭皮の洗浄
1プッシュを手に取り、泡の状態のままで頭皮に馴染ませます。頭皮全体に行き渡るように何度か繰りかえし、乾いたタオルで汚れを拭き取ります。
ボディの洗浄
適量をタオルに馴染ませてから、タオルで身体を拭きます。
手の洗浄
1プッシュを手に取り、乾燥するまでよく擦り込みます(タオルで拭き取る必要はありません)。
商品概要
商品名:水のいらないボディ&ヘアウォッシュ
容量 :150mL
価格 :1,200円(税抜)
販売店:ルバンシュ通販サイト( http://www.revanche.jp )など
※商品売上の一部は東日本大震災被災地区に寄付されます(2016年度は福島県いわき市薄磯地区に寄付いたしました)。
防災の日とは
1923年9月1日に関東大震災が起きたこと、また、暦の上で台風の多い210日に当たることから、1960年に制定されました。台風・高潮・地震などの災害に対する認識を深め、平時の備えについて確認する日とされています。
会社概要
商号 : 株式会社ルバンシュ
代表者 : 代表取締役 千田 和弘
所在地 : 〒923-1211 石川県能美市旭台2丁目5番地3
設立 : 1990年11月
事業内容: 化粧品および医薬部外品の製造・販売
資本金 : 1,000万円
お客様からのお問合せ
株式会社ルバンシュ
お問合せ・ご注文専用ダイヤル
0120-369-708(平日9:00~17:30)